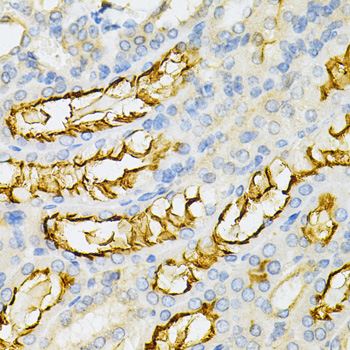
Immunohistochemistry - PPP2R4 Polyclonal Antibody

-
Product Name
PPP2R4 Polyclonal Antibody
- Documents
-
Description
Polyclonal antibody to PPP2R4
-
Tested applications
IHC, IF
-
Species reactivity
Human, Mouse, Rat
-
Alternative names
PTPA antibody; PP2A antibody; PPP2R4 antibody; PR53 antibody; protein phosphatase 2 phosphatase activator antibody
-
Isotype
Rabbit IgG
-
Preparation
Antigen: Recombinant fusion protein containing a sequence corresponding to amino acids 1-323 of human PPP2R4 (NP_821067.1).
-
Clonality
Polyclonal
-
Formulation
PBS with 0.02% sodium azide, 50% glycerol, pH7.3.
-
Storage instructions
Store at -20℃. Avoid freeze / thaw cycles.
-
Applications
IHC 1:50 - 1:200
IF 1:50 - 1:200 -
Validations

Immunohistochemistry - PPP2R4 Polyclonal Antibody
Immunohistochemistry of paraffin-embedded rat brain using PPP2R4 Antibody at dilution of 1:200 (40x lens).

Immunohistochemistry - PPP2R4 Polyclonal Antibody
Immunohistochemistry of paraffin-embedded human kidney cancer using PPP2R4 Antibody at dilution of 1:200 (40x lens).
Immunohistochemistry - PPP2R4 Polyclonal Antibody
Immunohistochemistry of paraffin-embedded human esophageal cancer using PPP2R4 Antibody at dilution of 1:200 (40x lens).

Immunohistochemistry - PPP2R4 Polyclonal Antibody
Immunohistochemistry of paraffin-embedded mouse kidney using PPP2R4 Antibody at dilution of 1:200 (40x lens).
-
Background
PPIases accelerate the folding of proteins. It catalyzes the cis-trans isomerization of proline imidic peptide bonds in oligopeptides. Acts as a regulatory subunit for serine/threonine-protein phosphatase 2A (PP2A) modulating its activity or substrate specificity, probably by inducing a conformational change in the catalytic subunit, a proposed direct target of the PPIase. Can reactivate inactive phosphatase PP2A-phosphatase methylesterase complexes (PP2A(i)) in presence of ATP and Mg(2+) (By similarity). Reversibly stimulates the variable phosphotyrosyl phosphatase activity of PP2A core heterodimer PP2A(D) in presence of ATP and Mg(2+) (in vitro). The phosphotyrosyl phosphatase activity is dependent of an ATPase activity of the PP2A(D):PPP2R4 complex. Is involved in apoptosis; the function appears to be independent from PP2A.
Related Products / Services
Please note: All products are "FOR RESEARCH USE ONLY AND ARE NOT INTENDED FOR DIAGNOSTIC OR THERAPEUTIC USE"
